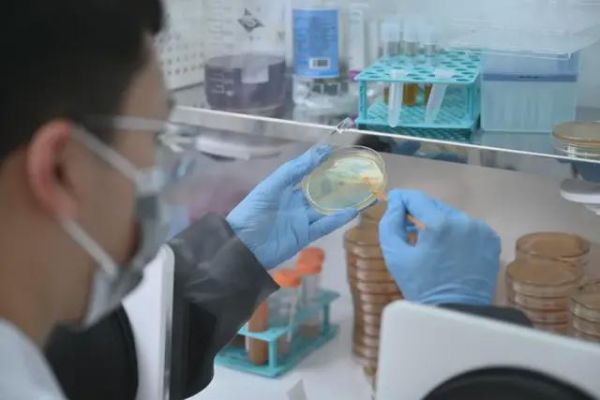

微生物制药是一个新兴且变量很大的赛道
文|《中国企业家》记者 谭丽平
编辑|张昊
图片来源|受访者
把细菌做成药物,这听起来有些“反常识”的事,未知君CEO谭验却坚信不疑。
未知君是国内第一批微生物制药公司,简单理解,就是利用与人体共生的各种肠道微生物来研发生产药物。最常见的产品是益生菌、膳食补充剂这些消费级产品,用于制药则是一个新兴且变量很大的赛道。相较于成熟的小分子等形态的药物,它还处于“婴儿阶段”,缺乏产业链来支撑,而制药本身又是一个长链条、长周期的事。
谭验渴望弯道超车。但在看到曙光之前,行业势必要经历很长一段隧道期——2022年前后,全球多家有过融资记录的微生物制药企业裁员、收缩管线、合作管线被退回,甚至有明星企业破产。一条新的制药路径想要证明自己的先进性,难度是“地狱级”的。
至今,美国FDA(食品药品监督管理局)仅批准了两款微生物药物,用于治疗艰难梭菌感染。这是美国很常见的医疗相关感染,2011年的数据显示,在50万感染者中约2.9万人死亡。
作为国内最早一批“吃螃蟹的人”,谭验有野心却不鲁莽。创业前的两年投资人经历,见过太多初创公司反而因融资太多,由盛转衰;创业之初,医生对微生物制药不熟悉,也不认可;他没放低难度,坚持中国和美国同时申报,就是为了升级团队能力;谭验内心想做药,但资本寒冬下可能会耗死公司,他快速调整策略,加速了益生菌这类更容易“造血”的消费品的开发。
这都是基于他确信的一个底层逻辑:做一个“平台”。“建立一个AI微生物研究平台,系统地研究分析人体内庞大的菌种,从中发现成药、医疗技术或消费品的机会,再推进研发。”这是一个他认为“能滚雪球的商业模式”。
这同样也很极客。人体住着数以万亿计的微生物,80%在肠道。平台一旦建立,且真正实现自运转,管线和产品就会像“流水线”一样持续涌现,看上去比现有的药物研发路径都要简单直接得多。
他认为,公司正在一步步接近这个理想中的状态,通过菌群移植治疗以及益生菌对外授权,公司的业务已经开始产生现金收入,“这意味着平台在商业逻辑上有了初步验证”。他相信,很快“就能够以一个完全独立的运转方式往前走”。
数据驱动的公司
他是投资人喜欢的那一类创业者,本科就读于北京大学生物技术专业,毕业后在麻省理工学院和哈佛大学合建的博德研究所从事博士研究,并获得了波士顿大学生物信息与计算生物学博士学位。强调“转化”的博德研究所,在过去20年培育出了多个纳斯达克上市公司创始人。
谭验在上学时就确定要创业,虽然没有具体的规划,但他“迷恋”数据,“数据驱动是一个很重要的方法论”。
2015年回国,在峰瑞资本当了两年投资人,他侧重数据驱动或AI驱动的制药公司,尽管“那时候还没有AI一说”。他投了晶泰科技,上学期间,就与公司的三位创始人相识。后来,晶泰科技成了“AI制药第一股”。
数据驱动、空间大、能够商业闭环,这是谭验思考商业模式的关键要素。2017年,他在深圳成立了未知君,在他看来,国内微生物和肠道菌群的市场几乎一片空白,能挖掘出来太多东西。
因为肠道里的微生物太多了,有数据表明人的肠道里有500~1000种菌,“如果再考虑多个菌种的共同作用,做一个排列组合,就更多了”。而当时虽然没有药物获批,但很多研究论文已经揭示了肠道菌群失调与多种疾病有直接关联,比如癌症、糖尿病、心血管疾病,甚至包括自闭症。
投资机构的履历让他清楚地知道这个赛道对应的潜在生意逻辑:微生物检测,主要用于科研和医院端的检测应用;消费端产品,包括益生菌、膳食补充剂等;药物研发,利用微生物对疾病做治疗。
那时市面上已经有很多微生物相关的测序产品了,卖得也不错。“但检测出来了,却没有(治疗性)产品,缺一个解决方案。”谭验首先排除了第一个路径。
后两者怎么选?尤其是不少投资人提出建议,做一个消费级品牌,因为那时的益生菌市场产品比较单一,有很多更细分的需求没有被挖掘出来。
他没下结论,只是做了一个决定:先从难一点但势能更高的制药做起。“一方面,国内乃至全球在这方面是空白;另一方面,在药物研发过程中,沉淀的技术平台能力,未来很容易延展到消费产品上,药的天花板相对高。”谭验说。
未知君创立的时点并不算一个“好时机”。当时,国际上对微生物制药的态度不明确,代表性事件是全球首款口服粪便微生物药物Vowst在2016年被宣布二期临床试验失败——中期分析中数据未达到主要终点。就在前一年,美国FDA还曾授予Vowst突破性疗法认证和孤儿药认证。消息传出后,这款药的所有者Seres Therapeutics市值蒸发了三分之二。
领域还是太新了。微生物药物的开发和投资热潮起始于2012年,美国FDA定义了一个新的类别——活体生物治疗产品(LBP),表明微生物治疗产品可作为药品进入市场。这只是开了一扇门,微生物药物在全球有一定共识发生在若干年后。2019年,欧洲明确了LBP的质量要求。2023年,FMT(肠菌移植)在中国作为医疗技术被列入医疗服务新增项目,无法以药品获批,只能将健康人粪便中的菌群移植到患者胃肠道内,从而治疗肠道疾病。
这些谭验都清楚,但在一个创业者眼中,没有规则就没有产业链,可以快速“抢地盘”。
只是过程很艰难。他起初时常要面对被否定和怀疑,“这条路径安全吗?有足够的价值吗?”他投入了很大精力去建立与医院和研究所的联系。第一个合作伙伴是北京大学肿瘤医院,花了一年半的时间才搞定,双方共同研究肠道菌群和现有肿瘤免疫治疗的关联。团队还专门组织了一支队伍在医院进行肠菌移植的宣传教育,收集粪便样本,最终才完成首批样本。

研究结果证实了相关性,谭验在一个国内顶级医院扯开了“口子”。未知君之后与国内近20家三甲医院建立了合作关系,开展针对不同适应症的临床研究。
2021年,未知君的明星管线XBI-302,获得了美国FDA的新药临床试验批准。这是国内微生物制药行业拿到的首个美国FDA临床批准,也是亚洲首个。目前,在肿瘤、神经系统、消化系统、免疫系统等疾病领域,未知君布局了十余条微生物药物管线,其中四条进入临床阶段。
笃信平台
在2022年之前,未知君完成了5轮融资,谭验的平台逻辑很吸引投资机构的兴趣。尤其是近几年,在ADC(抗体药物偶联物)这个有平台特征的赛道中,中国创新药企大规模反向授权给国外公司。谭验说,医药行业从开始的依靠引入,到现在有自己的研发能力,这就是平台的作用。
“最初关注的是麦当劳、可口可乐这类品牌型技术公司,但随着商业更加深入,大家更愿意挖掘产业链中更牛的公司,如宁德时代、英伟达。平台型的企业能做得更大,且有更长期的商业价值。”在他看来,一旦平台型公司自运转起来,就能形成很高的技术壁垒。
但2022年,国内创新药行业进入资本寒冬。对于谭验的直接影响就是要马上学会“造血”,毕竟平台型公司的构建是一个漫长的过程,先要活下去。
不过这时候,平台型公司的优势也体现出来:产品多。谭验快速要求团队推动对外“授权”,除了跟一些药企合作之外,也开辟了益生菌产品线,跟一些消费品公司合作。

实际上,最初谭验给未知君设计的路径就是“融资+里程碑”。后者通过产品和知识产权授权给合作伙伴,拿到一定首付款之后,在后续的各个节点还能拿到一定分成,这是初创平台型公司常规的商业模式。“可能每一个产品上我赚的钱绝对值会少,但是能合作的伙伴多,未来的空间就会更大。”谭验说。
只是所有规划需要提前,如果融资不通畅,授权就得提速。如今路径虽然跑通了,但离大规模复制还有一定距离。谭验觉得,商业化团队本身需要磨合,也需要跟技术团队去磨合。前者是团队过去涉猎商业化较少,后者则是基于更深的商业思考:怎么通过对市场信息的捕捉,使内部去研发更加针对市场需求的产品?
为此,他摸索出了一套独特的矩阵式管理架构。研发平台是企业的“中后台”,由AI组、微生物组、分子组、体内体外验证组等构成,主要负责完成研发平台的搭建和运行。而前端会按照不同的业务构成,形成药、医疗技术、消费品等灵活的项目组,根据需求调用平台资源就好。这个架构看上去更接近于一家互联网公司,也是谭验面对不同场景的解法。
资本虽然没回暖,但行业环境在快速向好。几个重要国家对行业的标准定义更清晰,包括益生菌产品在疫情期间也有了一个大爆发,这都给谭验创造了很多新机会。上文提到的Seres Therapeutics在之后裁员30%,将资源集中于少数几个临床开发项目上,反而又让Vowst成功获批了。这个赛道开始走向台前,成为创新药行业的重要前沿领域之一。

2023年开始,谭验明显感觉到了变化,他期待的那个平台正在产生正回报。整个组织的研发效率越来越高,“有条不紊的感觉,我觉得这对研发来说是最重要的效率体现”。
今年,他要推动在授权之外,把“销售”路径也跑通。在国内市场,向医院、体检机构推广FMT产品,这牵扯到搭建销售团队。“怎么理解市场,怎么建立销售渠道,每一步都有很多的困惑、痛苦和煎熬。”谭验说。
如果“授权+销售”都跑通,未知君在商业化上就是两条腿走路。到那时,融资路径也会更容易打通,这是他心里最理想的状态。这个人类涉足甚少的领域,将迸发出多大的能量,谁都不知道。但它足够吸引人,谭验也想用自己的方式去蹚一条独特的路出来。
相关推荐
用细菌做药,估值20亿,这个北大学霸5年融5轮
估值20亿的明星创业公司11亿被并购,VC乱给估值终惨交学费
两个北大学霸,3年融资十几亿,要“复刻”万物
估值70亿元的独角兽凉了,5年融不到钱
又一巨无霸奔赴IPO:两位大学室友合伙,做出2000亿估值
奔赴IPO的Airbnb:两位大学室友合伙,做出2000亿估值
他们,90后天才学霸,VC投疯了
一个冥想APP就能估值20亿美金,VC们都想不明白
三个90后,估值360亿:黄仁勋的座上宾
36氪首发 | 加速企业级AI基础设施建设,「第四范式」完成C+轮融资,估值约20亿美元
网址: 用细菌做药,估值20亿,这个北大学霸5年融5轮 http://m.xishuta.cn/newsview124363.html